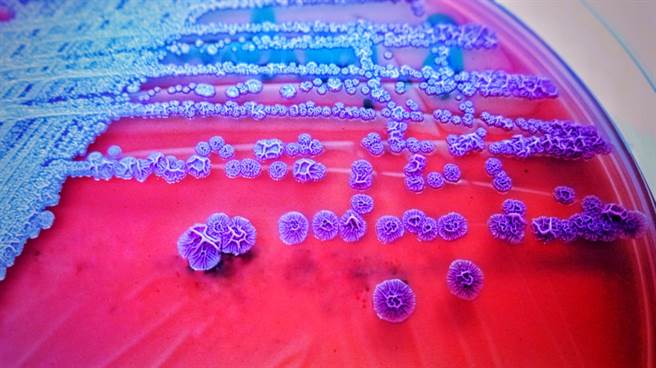
美国本土首次出现只有热带气候地区才会有的类鼻疽病（melioidosis），目前已有4人感染，当中2人死亡，感染源仍不明。（示意图／shutterstock）

美国本土首次出现只有热带气候地区才会有的类鼻疽病(melioidosis),目前已有4人感染,当中2人死亡,感染源仍不明。
科技新闻网站「生活科学」(Live Science)报导,美国疾病管制暨预防中心(CDC)9日通报,美国本土出现4起类鼻疽病病例,这些人是在3月至7月间确诊,分别分布在乔治亚州、堪萨斯州、德州及明尼苏达州,当中2人不幸病逝,另外2人住院好长一段时间才康復。
其中一名患者还是身体相当健康的4岁小女孩,她在加护病房住了一个月,期间需要呼吸器辅助,脑部也受损,小女孩目前仍未完全康復。
值得注意的是,类鼻疽病是一种热带气候疾病,由类鼻疽杆菌(Burkholderia pseudomallei)引起,这种病菌主要在热带气候中生长,常见于东南亚及澳洲北方,美国领土也有这种病菌生长,不过是在加勒比海地区的波多黎各及维京群岛。
另外美国本土每年也有约10多例类鼻疽病病例,不过几乎全是境外移入,确诊者都有相关地区旅游史,这4起案例最不寻常的地方在于4名患者都没有相关旅游史。
美国CDC已经检测了超过100项确诊者住家周遭的物品、土壤及水质样本,没有样本检测出类鼻疽杆菌。
另外CDC指出,经过病菌基因定序,这4名患者身上的菌株相似,可能有共同感染源,而且和东南亚的菌株相近,官员怀疑,患者可能是从进口的物品感染病菌,可能的来源包括食品、饮料、个人护理及清洁产品。
报导指出,人类接触到类鼻疽杆菌后,通常需要数周时间才会发病,让卫生官员追踪感染源的工作变得更加困难。
类鼻疽病的症状相当广泛,这4名患者分别经歷了咳嗽、呼吸困难、虚弱、疲惫、噁心、呕吐、间歇性发烧、以及躯干、腹部、脸部长疹子等各式各样症状。
CDC指出,有潜在健康问题的民眾,罹患类鼻疽病的风险较一般人高,主要风险因子包括糖尿病、肝臟、肾臟疾病、慢性肺部疾病、癌症,或是其他削弱免疫系统的症状。
美国的这4名患者中,有2人本身有危险因子,不过另外2人没有相关因子。
发表意见
中时新闻网对留言系统使用者发布的文字、图片或檔案保有片面修改或移除的权利。当使用者使用本网站留言服务时,表示已详细阅读并完全了解,且同意配合下述规定:
违反上述规定者,中时新闻网有权删除留言,或者直接封锁帐号!请使用者在发言前,务必先阅读留言板规则,谢谢配合。